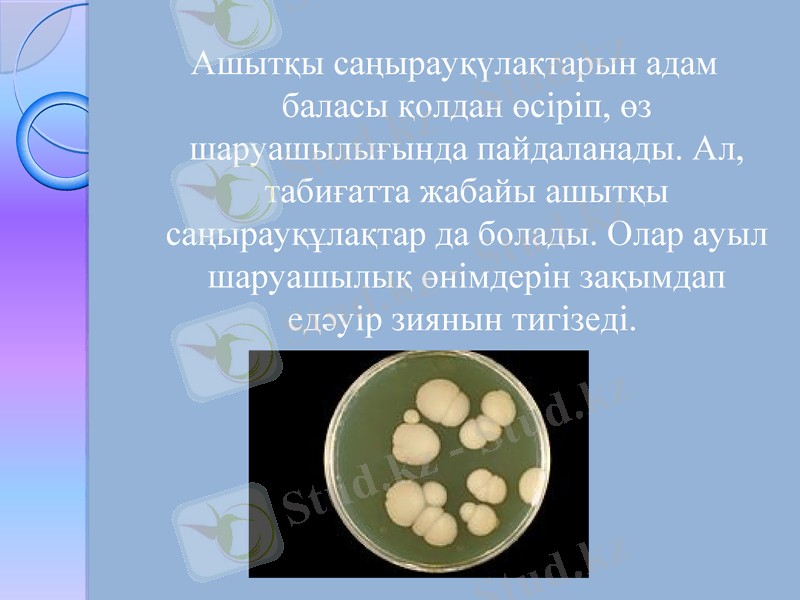
Slide 6

Өнеркәсіпте қолданылатын ашытқы саңырауқұлақтардың қасиеттері мен қолданылуы



Өнеркәсіпте қолданылатын дрожжилар
Орындаған: Мансұрова Анель, БТ-407

Жоспар:
Ашытқы
Өнеркәсіпте қолданылуы
Қорытынды
Пайдаланылған әдебиеттер

Ашытқы
Ашытқылар - бір жасушалы, мицелийлері жоқ, бүршіктенетін саңырауқұлақтар. Олар аскомицеттер класына жатады. Жасушаларының формасы сопақ, дөңгелек, лимон тәріздес болып келеді. Олардың жасушаларының қабығы, цитоплазмасы және боялмаған препараттарда айқын көрінетін ядросы болады. Жас жасушалардың цитоплазмасы біркелкі, ал ересектерінде вакуольдер пайда болады.

Басқа түрлерден ерекшелігі мицелийі жоқтығы. Органикалық затқа толы сулы және жартылай сулы ортада өмір сүреді. Олар бөлінген немесе топталған түрде өмір сүреді. Бұндай құрылымы оларға зат алмасуының максималды тез өтуіне көмектеседі. Сондықтан тез өсіп жетіле алады.

Ашытқылар микробтарға қарағанда біршама үлкен, орардың диаметрлері 10-15 мкм-ге дейін жетеді. Ашытқы жасушасының ішінде спора түзілген соң олар сумкалар (аскалар) деп аталады. Спораларының саны 4-12-ге дейін барады. Ашытқы жасушалары тынышталған түрінде де кездеседі. Олар вегетативті формалардан екі қабатты қабығымен, қоректік заттарының молшылығымен және вакуольдердің жоқтығымен ажыратылады. Ашытқылар бүршектену арқылы, спора немесе жыныстық жолдарымен көбейеді.
Ашытқы саңырауқүлақтарын адам баласы қолдан өсіріп, өз шаруашылығында пайдаланады. Ал, табиғатта жабайы ашытқы саңырауқұлақтар да болады. Олар ауыл шаруашылық өнімдерін зақымдап едәуір зиянын тигізеді.

19000 еселеп көрсетілген сурет

Өнеркәсіпте қолданылуы
Ашытқы саңырауқұлақтар өнеркәсіпте кең қолданылады. Олар қантты ашытып, көмір кышқыл газы мен спирт түзеді. Олардың бұл қасиеті нан өндірісінде және спирт өндіруде, түрлі шараптарды, сыраларды, сүт тағамдарын даярлауда қолданылады. Ашытқы саңырауқүлақтарында белок және витаминдер (В, Д, Е) көп болады, сондықтан оларды қазір тамақ және мал азықтық мақсатқа кеңінен қолданады.

Адамдар микроорганизмдер мен саңырауқұлақтарды тамақ өндірісінде және сыра жасауда кеңінен қолданады. Ашытқы қазіргі заманғы сыра жасауда ең қажетті зат болып табылады. Оның көмегімен сырада этил спирті, көмірқышқыл газы түзіледі, яғни әлсіз алкогольденген сыра пайда болады.

Қорытынды
Қарапайым мәнде ашытқы дегеніміз - тағамдық ортаға қосқанда ашу процесін түзетін кез келген органикалық зат. Бұл мағынада аспаздық тәжірибесінде ашытқыларға шарап сірке суы, құрғақ, қышқыл жүзім шарабы, сыражатады, олар тез, бірақ қысқа мерзімге әрекет етеді.

Пайдаланылған әдебиеттер:
Жалпы микробиология
monbeer. ru
Wikipedia. org
- Іс жүргізу
- Автоматтандыру, Техника
- Алғашқы әскери дайындық
- Астрономия
- Ауыл шаруашылығы
- Банк ісі
- Бизнесті бағалау
- Биология
- Бухгалтерлік іс
- Валеология
- Ветеринария
- География
- Геология, Геофизика, Геодезия
- Дін
- Ет, сүт, шарап өнімдері
- Жалпы тарих
- Жер кадастрі, Жылжымайтын мүлік
- Журналистика
- Информатика
- Кеден ісі
- Маркетинг
- Математика, Геометрия
- Медицина
- Мемлекеттік басқару
- Менеджмент
- Мұнай, Газ
- Мұрағат ісі
- Мәдениеттану
- ОБЖ (Основы безопасности жизнедеятельности)
- Педагогика
- Полиграфия
- Психология
- Салық
- Саясаттану
- Сақтандыру
- Сертификаттау, стандарттау
- Социология, Демография
- Спорт
- Статистика
- Тілтану, Филология
- Тарихи тұлғалар
- Тау-кен ісі
- Транспорт
- Туризм
- Физика
- Философия
- Халықаралық қатынастар
- Химия
- Экология, Қоршаған ортаны қорғау
- Экономика
- Экономикалық география
- Электротехника
- Қазақстан тарихы
- Қаржы
- Құрылыс
- Құқық, Криминалистика
- Әдебиет
- Өнер, музыка
- Өнеркәсіп, Өндіріс
Қазақ тілінде жазылған рефераттар, курстық жұмыстар, дипломдық жұмыстар бойынша біздің қор #1 болып табылады.



Ақпарат
Қосымша
Email: info@stud.kz